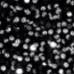

Similar products
Similar products

Color
Ecru
Shipping & policies
- Estimated delivery Jan 14-23
Free and easy returns. Learn more
With Faire, shop unique wholesale products for your store from brands like LUCCE and more.
Description
Knit dress, flared cut with a round neckline and flared sleeves. Pleated hem.
This info has been automatically translated.
Details
Made in China Weight: 0.5 kg (1.1 lb)